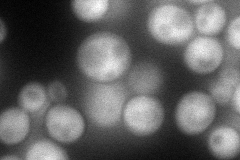
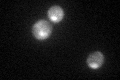

View description
Sulfiredoxin, contributes to oxidative stress resistance by reducing cysteine-sulfinic acid groups in the peroxiredoxins Tsa1p and Ahp1p that are formed upon exposure to oxidants; conserved in higher eukaryotes
Localization:
Intensity:
Fold change:
Significance:
-
C’ GFP library in SD

cytosol30.71 -
N' NOP1pr-GFP in SD
cytosol79.7434 -
N' TEF2pr-mCherry in SD

cytosolN/A -
N' NATIVEpr-GFP in SD

cytosol33.4718 -
N' TEF2pr-VC and Cyto-VN in SD

cytosol43.5081 -
C’ GFP library in SD+DTT

cytosol35.861.16No -
C’ GFP library in SD+H2O2

cytosol188.956.15Yes -
C’ GFP library in Starvation Media
cytosol83.92.73Yes -
C’ GFP library on the background of Pup2-DaMP

cytosol -
C’ GFP library on the background of CCT mutant

cytosol26.70020.869159No
